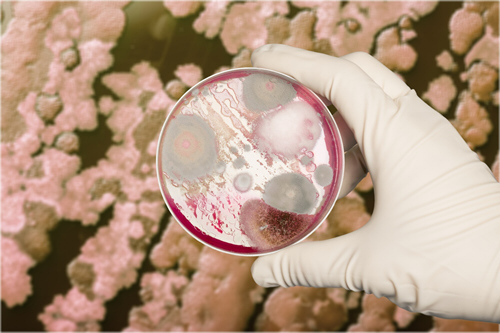

UKRAGREXIM LTD is a company with Ukrainian State
participation and established as joint venture company by Poltava National
Agrarian University and Agrofertrans LTD.
The company is focused on research, technology development and project management in the fields of ecology, sustainable agriculture,
argobiotechnology, organic farming and growing cereals, vegetables, legumes and
other crops.

Growing of cereals, vegetables, legumes and other crops and as well as exports worldwide

Manufacture of biofertilizers, biostimulants, biopesticides and bioadditives for biomineral and organomineral fertilizers
Construction of reservoirs, barrages, regulators, drainages, irrigation systems, other structures for water and flood control

Excavation/ Dredging of water ways, Rivers, Capital Dredging for port and Deep sea port

Innovative biotechnologies for agriculture and soil and water bodies remediation

"We are convinced that sustainability and environmental safety of agricultural production possible only under eco-friendly conditions!"
Company invests intellectual resources
and funds for:
- Creation of new
biotechnological products for plant nutrition and protection, reduction
of soil contamination by xenobiotics and heavy metals, phytoremediation of
industrial area soils.
- Research of physiological and
biochemical properties of new products, their stability and manufacturability.
- Study of the biological
efficiency of new innovative products, their impact on the environment and
safety for human.
- Development of the newest
technologies for effective ecologically safe cultivation of crops for sustainable agriculture.
- Development of
biotechnological methods for remediation of water bodies.
- Public actions to promote the
modern ecofriendly agrotechnologies against desertification and global warming
to ensure of world’s food security.

The company has close scientific and business
relationships with Ministry of Ecology and Natural Resources of Ukraine, Poltava State Agrarian University, Institute of Microbiology and Virology of NAS of Ukraine, State Water Resources Agency of Ukraine, Institute of Agricultural Microbiology, Institute of Agroecology and
Environmental Management, Skvyra Research Station of Organic Farming, Institute
of Feeds and Agriculture of Podillya, Kundiiev Institute of Occupational
Health, etc.
Cooperation
In cooperation with scientific institutions was
created our innovative products and technologies, which allow:
Renew
quality of soil and water
Increase
plant resistance to pest
Implement ecofriendly technology
Reduce
usage of agrochemicals
created with
Website Builder Software .